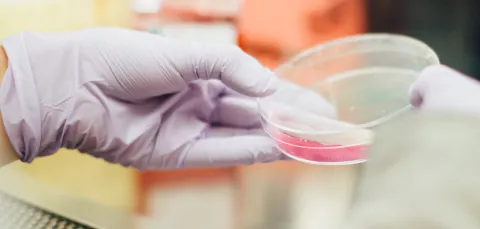
Close-up of a petri dish in a scientist's gloved hands

Southampton Clinical Trials Unit’s mission is to create the evidence for better treatments for patients.
Learn more about the goals and values that underpin our work.
Read our strategy
Read our equality, diversity and inclusion strategy
Our 3-year EDI strategy sets out SCTU's commitment to making health research inclusive for all, and outlines our aims and objectives up to 2025.
Read our patient and public involvement strategy
In April 2022, we set out our 3-year strategy for patient public involvement (PPI) at Southampton Clinical Trials Unit.